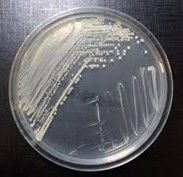

MEDIOS PREPARADOS
Vea nuestro listado de productos.
FRASER
Caldo formulado para el enriquecimiento e identificación de Listeria..
PLACAS DE AGAR BAIRD PARKER / CROMOCOLI PLACAS DE 10 CM
Placas dobles con Medio Cromo-génico para E. Coli y Medio Baird Parker para S. Aureus. El medio CromoColi es un agar selectivo para la detección simultanea de Escherichia coli y recuento total de coliformes en manipuladores de alimentos. El medio Baird Parker es un medio de cultivo selectivo para el cultivo, aislamiento, diferenciación del Staphylococcus Aureus. .
AGAR RECUENTO TOTAL PLACAS DE 10 CM
Recuento Total (RAM) El agar Recuento total es un medio utilizado para la enumeración de bacterias aeróbicas en aguas, aguas residuales y alimentos. .